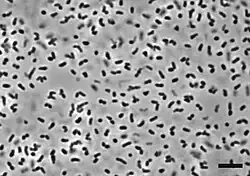

Caenimicrobium
Caenimicrobium es un género de bacterias gramnegativas de la familia Alcaligenaceae. Actualmente (2023) sólo contiene una especie: Caenimicrobium hargitense. Fue descrito en el año 2017. Su etimología hace referencia a lodo. El nombre de la especie hace referencia a Hargita, el nombre en latín de las montañas Harghita, Rumania.[1] Es aerobia e inmóvil. Tiene un tamaño de 0,6-0,8 μm de ancho por 1,1-2,2 μm de largo. Catalasa y oxidasa positivas. Forma colonias circulares, elevadas y de color beige. Temperatura de crecimiento entre 4-65 °C. Tiene un contenido de G+C de 62,3%. Se ha aislado de lodos activados de un biorreactor en Rumania.
| Caenimicrobium hargitense | ||
|---|---|---|
![]() | ||
| Taxonomía | ||
| Dominio: | Bacteria | |
| Filo: | Pseudomonadota | |
| Clase: | Betaproteobacteria | |
| Orden: | Burkholderiales | |
| Familia: | Alcaligenaceae | |
| Género: |
Caenimicrobium Felföldi et al. 2017 | |
| Especie: | Caenimicrobium hargitense | |
Referencias
- Felföldi, Tamás; Schumann, Peter; Mentes, Anikó; Kéki, Zsuzsa; Máthé, István; Tóth, Erika M. (2017-04). «Caenimicrobium hargitense gen. nov., sp. nov., a new member of the family Alcaligenaceae (Betaproteobacteria) isolated from activated sludge». International Journal of Systematic and Evolutionary Microbiology 67 (3): 627-632. ISSN 1466-5034. PMID 27902326. doi:10.1099/ijsem.0.001674. Consultado el 13 de junio de 2023.
Este artículo ha sido escrito por Wikipedia. El texto está disponible bajo la licencia Creative Commons - Atribución - CompartirIgual. Pueden aplicarse cláusulas adicionales a los archivos multimedia.